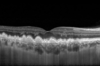

Une offre d’ophtalmologie variée dans l’agglomération de Châlons en Champagne et Epernay
Notre Offre de Soins

Bilan Visuel
Le bilan visuel comporte :
- Une mesure de votre réfraction (Myopie, Astigmatisme, Hypermétropie, Presbytie) afin de vous prescrire des lunettes et lentilles de contact.
- Un examen médical complet afin de dépister les principales pathologies oculaires (Glaucome, DMLA, Kératocône, Cataracte…) incluant : une Tonometrie, une Pachymetrie, une Rétinographie, et une Tomographie à coherence optique ( OCT) du nerf optique et de la rétine.
En cas de suspicion d'une pathologie, d'autres examens complémentaires pourraient vous être proposés.
Un compte rendu de consultation vous sera fourni systématiquement.
Pathologie Rétinienne
Les maladies de la rétine sont principalement la DMLA (Dégénérescence Maculaire Liée à l'Age), la rétinopathie et maculopathie diabétique, les accidents vasculaires de l'œil tels que les occlusions artérielles ou veineuses de la rétine, les choriorétinites séreuses centrales, les dystrophies maculaires héréditaires. A l'aide d'une imagerie performante, nous établirons un diagnostic précis. En fonction du diagnostic, nous vous proposerons un traitement : laser rétinien, injections intra vitréennes ou autre.

Glaucome
Le glaucome est une maladie chronique qui peut entrainer la cécité définitive en l’absence de traitement. Elle correspond à une destruction progressive du nerf optique entrainée dans la majorité des cas par une pression intraoculaire excessive.
Le plus souvent, le patient ne présente aucune gêne. Le diagnostic se fera lors d’une consultation systématique, à l’occasion d’un renouvellement de lunettes par exemple.
La mesure de pression intraoculaire qui est faite à chaque consultation permet ce dépistage. Votre médecin vérifiera ensuite l’aspect de votre nerf optique en vous examinant (même sans dilatation).
En cas d’anomalie, Nous possèdons tous les outils nécessaire à l’évaluation et au traitement de votre glaucome : OCT, pachymétrie, champ visuel, laser SLT…
Le glaucome chronique se soigne avec une ou plusieurs gouttes. Il peut parfois être nécessaire d’avoir recours au laser ou à la chirurgie.

Myopie de l'enfant
La myopie est le plus souvent due à un œil trop long. Les rayons lumineux
convergent en avant de la rétine et la vision de loin est floue car l’image ne se forme pas sur la rétine mais en avant. Par contre, la vision de près est nette et permet de lire sans lunettes souvent de façon très rapprochée.
Cette anomalie concerne environ 30% de la population occidentale et est plus fréquente en cas d’antécédents familiaux : le risque d’apparition d’une myopie chez un enfant est plus important si l’un ou les deux parents sont myopes.
Ce trouble réfractif apparaît habituellement dans l’enfance vers 6 à 8 ans et évolue jusqu’à l’âge adulte.
Plus elle commence tôt, plus elle peut être évolutive et importante.
La myopie habituellement rencontrée n'est pas une maladie mais elle augmente les risques de maladie (cataracte, glaucome...) et de souffrance de la rétine (particulièrement les myopies de - 6D et plus).
Il existe actuellement un arsenal thérapeutique permettant de ralentir la myopie, n'hésitez pas à en parler à votre ophtalmologiste.

Injection intra vitréenne (IVT)
Il s’agit de l’injection de substances médicamenteuses directement à l’intérieur de l'œil dans la cavité vitréenne.
Ce traitement montre une efficacité dans de nombreuses maladies oculaires, en particulier la dégénérescence maculaire liée à l’âge (DMLA), la maculopathie diabétique et les occlusions veineuses rétiniennes. Non traitées, elles ont pour conséquence une détérioration progressive de la vision.
Une série d’injections est nécessaire dans la plupart des cas. Elles sont habituellement espacées de quatre à douze semaines.

Chirurgie de la Cataracte
La cataracte se caractérise par une baisse progressive de l’acuité visuelle due à une opacification du cristallin
Le traitement chirurgical de la cataracte consiste à enlever le noyau du cristallin opacifié au travers d’une petite incision afin de rétablir sa transparence. Le cristallin naturel atteint de cataracte est ensuite remplacé par un implant intraoculaire (lentille artificielle). Les consultations préopératoires sont nécessaires pour choisir l’implant le plus adapté à vos yeux. Les examens préalables permettent également de connaître les contre-indications et les précautions à adopter avant et après l’opération.

Chirurgie de la Rétine
La chirurgie vitréo-rétinienne peut être réalisée dans le cadre d'un Trou maculaire, d'une Membrane épirétinienne, d'une Traction vitréo-maculaire, d'un Décollement de rétine, d'une Luxation de cristallin, d'une Luxation d'implant artificiel ou d'une Implantation secondaire d'un cristallin artificiel.

Chirurgie Réfractive
La chirurgie réfractive est une chirurgie fonctionnelle visant à améliorer la qualité de vie en diminuant la dépendance aux lunettes.
Lors de la consultation, nous réalisons un ensemble d’examens afin d’éliminer une éventuelle contre-indication à l’opération, et choisir la meilleure technique de chirurgie des yeux pour chacun ( Laser ou autre technique). La consultation permet également une mesure très précise de la correction optique à corriger.
